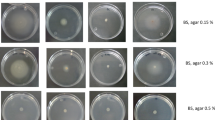

Abstract
Flagellum mediated motility is an essential trait for rhizosphere colonization by pseudomonads. Flagella synthesis is a complex and energetically expensive process that is tightly regulated. In Pseudomonas fluorescens, the regulatory cascade starts with the master regulatory protein FleQ that is in turn regulated by environmental signals through the Gac/Rsm and SadB pathways, which converge in the sigma factor AlgU. AlgU is required for the expression of amrZ, encoding a FleQ repressor. AmrZ itself has been shown to modulate c-di-GMP levels through the control of many genes encoding enzymes implicated in c-di-GMP turnover. This cyclic nucleotide regulates flagellar function and besides, the master regulator of the flagellar synthesis signaling pathway, FleQ, has been shown to bind c-di-GMP. Here we show that AdrA, a diguanylate cyclase regulated by AmrZ participates in this signaling pathway. Epistasis analysis has shown that AdrA acts upstream of SadB, linking SadB with environmental signaling. We also show that SadB binds c-di-GMP with higher affinity than FleQ and propose that c-di-GMP produced by AdrA modulates flagella synthesis through SadB.
Similar content being viewed by others
Introduction
The pseudomonads are motile bacteria able to swim and swarm by means of polar flagella. Flagella are also used in the initial attachment of bacteria to surfaces1, and are therefore important for biofilm formation2. Flagellar motility is an important trait for rhizosphere colonization3,4,5. In the biocontrol model bacterium Pseudomonas fluorescens F113, it has been shown that hypermotile variants arise during rhizosphere colonization6 and that this trait is more important than the ability to form biofilms for the competitive colonization of the rhizosphere7.
Biosynthesis of the flagellar apparatus is an energetically expensive process that requires the expression of many genes and therefore, it is tightly controlled. A regulatory cascade initiated by the master regulator FleQ and the sigma factor FliA results in the ordered production and assemblage of the flagellar components resulting in a functional flagellum8,9. However, the initiation of this regulatory cascade is also affected by environmental cues and as-yet unknown signals. We have previously shown that in P. fluorescens F113 two signal transduction pathways, one initiated by SadB and the other by the GacA/GacS two component system converge in the production of the AlgU sigma factor10. This sigma factor is required for the expression of the amrZ gene, which encodes a global and bifunctional transcriptional regulator, implicated in the expression of hundreds of genes both in P. fluorescens F11311 and Pseudomonas aeruginosa12. AmrZ is a strong transcriptional repressor of the gene encoding the flagellar master regulator FleQ in both strains10,13.
Bis-(3′-5′)-cyclic dimeric guanosine monophosphate (c-di-GMP) is also an important player in processes related to motility and biofilm formation14. Low c-di-GMP levels are associated with high motility and a planktonic life-style, while high levels are associated with the production of exopolysaccharides and biofilm formation and therefore, with a sessile life-style15. Intracellular levels of c-di-GMP are the result of the action of two types of enzymes, diguanylate cyclases (DGCs) and phosphodiesterases (PDEs), which carry out the synthesis and degradation of this molecule respectively16. DGCs are proteins that contain GGDEF domains17, while PDEs either contain EAL15 or HD-GYP18 domains.
c-di-GMP has been implicated in the control of flagellar function in pseudomonads and other bacteria, including the energization of the apparatus through the FliI ATPase19, control of the rotation speed20,21 and the reversal frequency22. However, the implications of c-di-GMP for flagellar biosynthesis has been less investigated. We have recently shown that AmrZ is a major determinant of c-di-GMP levels in P. fluorescens F113 by controlling the transcription of multiple genes encoding DGCs, PDEs and c-di-GMP sensing proteins23. The master regulator FleQ24. has been shown to bind c-di-GMP and binding of this cyclic dinucleotide to FleQ represses flagella synthesis25. The aim of this work was to study the possible role of c-di-GMP in the biogenesis of the flagellar apparatus, as well as to find novel proteins involved in its production and sensing that affect this process in P. fluorescens F113.
Results
AdrA is a membrane associated diguanylate cyclase
Sequence analysis by HMMER26 using profile hidden Markov models and the Pfam database showed that AdrA (PSF113_1982) is a membrane associated protein with an N-terminal extracellular MASE2 domain27 and a C-terminal, cytoplasmic GGDEF domain (Fig. 1a). The MASE2 domain contains four predicted transmembrane helices (Fig. 1a) that would link the protein to the cytoplasmic membrane, forming a receptor for as-yet unknown signals. We have previously shown23 that an adrA− mutant in P. fluorescens F113 shows increased motility (Supplementary Fig. 1) and a reduction in its attachment to surfaces. In order to confirm the diguanylate cyclase activity of the GGDEF domain, adrA was ectopically expressed in E. coli DH5α and P. fluorescens F113. As shown in Fig. 1b, overexpression of adrA resulted in a decrease in swimming motility and an increase in the attachment to surfaces, which is consistent with an increase in c-di-GMP caused by overexpression of a DGC. Moreover, c-di-GMP intracellular measurements in the adrA mutant reveal very low levels of this second messenger in the mutant in comparison with the wild-type strain as shown in Fig. 1c. Taken together, these results indicate that the membrane bound AdrA protein possesses DGC activity.
AdrA encoded by PSF113_1982 in Pseudomonas fluorescens F113 is a DGC. (a) Predicted domain organization for AdrA protein (352 aa) from P. fluorescens F113 according to HMMER using profile hidden Markov models and Pfam database. Domains are indicated in each block. Domains (MASE2 and GGDEF) and their individual E-values are shown above. Signal peptide (SP, brown rectangle) and transmembrane domains (TM, grey rectangles) are shown below. Numbers indicate the start and end aa positions covered by each domain or feature. (b) Relative swimming motility in DH5α and P. fluorescens F113 and relative biofilm formation in P. fluorescens F113 in AdrA overexpression experiments. pBBRMCS-5 vector harbouring adrA from P. fluorescens F113 was used for overexpression experiments in both strains. The empty pBBRMCS-5 vector was used as control. Mean ± SD of three replicates are shown. Statistically significant difference (p < 0.05) are denoted by asterisks. (c) AdrA participates in the synthesis of the second messenger c-di-GMP. Streaks on LB medium of P. fluorescens F113 and its adrA mutant harbouring the gfp-based pCdra biosensor for c-di-GMP. Pictures were obtained in a Leika binocular microscope with a GFP filter set and 50 miliseconds of exposition time. Intracelullar levels of c-di-GMP were measured as fluorescence emission in the pCdra-containing strains. Mean ± SD of five analyzed extracts per strain are represented. Asterisks denote statistical significance of the data (****p < 0.0001).
AdrA regulates flagella synthesis
In order to determine whether AdrA participates in the regulation of flagella synthesis, we tested the expression of the fliC gene in P. fluorescens F113 and its adrA mutant background. As shown in Fig. 2, expression of fliC is significantly higher in the adrA mutant. SadB is a signal transduction protein that has been shown to regulate flagella synthesis in F11310,28. Consistent with this, similar results were obtained in a sadB− background. Together, these results show that AdrA and SadB participate in the regulation of flagellar gene expression and therefore in flagella synthesis.
AdrA regulates the expression of the flagellar gene fliC. RT-qPCR analysis of fliC expression in Pseudomonas fluorescens F113 and its adrA and sadB mutant backgrounds. Gene expression was normalized with rpoZ and relativized to wt. Mean ± SD of three replicates are shown. Asterisks indicate statistically significant differences (***p < 0.001, ****p < 0.0001).
AdrA contributes to the SadB signaling pathway but acts independently of the GacAS system
In order to investigate the participation of AdrA in the flagella biosynthesis pathway, we constructed a double mutant in the adrA and sadB genes. As shown in Fig. 3a, the sadB mutant showed a hypermotility phenotype stronger than the adrA mutant. The double mutant showed a non-additive phenotype, indicating genetic interaction between adrA and sadB. Furthermore, the double mutant showed a phenotype identical to the phenotype of the sadB mutant, suggesting that AdrA acts upstream of SadB in the flagella synthesis regulatory pathway. We also tested the possible interaction of adrA with gacS, a gene that acts in the flagella synthesis regulatory pathway independently of sadB10. As shown in Fig. 3b, the adrAgacS double mutant showed an additive phenotype in comparison with the swimming motility pathways of the individual mutants. These results indicate that AdrA and GacS act independently in the regulation of flagella synthesis in P. fluorescens F113.
AdrA regulates flagellar synthesis through SadB and independently of Gac/Rsm pathway in Pseudomonas fluorescens F113. Relative swimming motility of P. fluorescens F113, simple or double mutants affected in adrA and sadB (a) or gacS (b) genes. Mean ± SD of three replicates are shown. Different letters indicate statistically significant differences (p < 0.05).
SadB binds c-di-GMP
The SadB protein contains two domains of unknown function. The N-terminal YbaK-like domain has been suggested to bind nucleotides or oligonucleotides29. Furthermore, the C-terminal HDOD domain resembles the PDE HD-GYP domain. However, the HDOD domain does not possess catalytic activity and it has been suggested that it might bind c-di-GMP30. Considering the presence of these two domains and the AdrA DGC activity upstream of SadB, we decided to test whether SadB binds c-di-GMP. N-tagged HA-SadB protein was produced and gel filtration showed an apparent MW compatible with a dimeric conformation both in the presence or absence of c-di-GMP (data not shown). Surface Plasmon Resonance (SPR) analysis of HA-SadB in the presence of c-di-GMP showed that the protein was able to bind the cyclic nucleotide with a dissociation constant (Kd) of 0.23 µM (Fig. 4A). The specificity of the binding was then confirmed using a pull-down assay with biotinylated c-di-GMP (Fig. 4B), which shows that streptavidin precipitation of the SadB protein could be disrupted by addition of free c-di-GMP but not by GTP.
SadB is a c-di-GMP binding protein in Pseudomonas fluorescens F113. (A) SPR affinity fit curve describing SadB-c-di-GMP binding. (B) Streptavidin UV Precipitation (SUPr) assay. Biotinylated c-di-GMP was used for the precipitation of SadB from an induced lysate. Free c-di-GMP and GTP were used as competitors.
Discussion
Biogenesis of the flagellar apparatus in pseudomonads is activated by the master regulator FleQ, which initiates a regulatory cascade8. In Pseudomonas fluorescens F11310 and in P. aeruginosa12, the expression of the fleQ gene is transcriptionally repressed by AmrZ, a bifunctional regulator whose expression depends on the sigma factor AlgU13. Additionally, a reciprocal transcriptional repression between FleQ and AmrZ has been shown in P. fluorescens F11331. In this strain, expression of algU is under the control of two convergent pathways: the Gac/Rsm pathway and the SadB pathway10.
The role of c-di-GMP in the regulation of flagellar synthesis is evident at different levels. First, it has been shown that FleQ is a c-di-GMP binding protein24 that in response to cyclic nucleotide binding functions either as a transcriptional activator or as a repressor32. Thus, high levels of c-di-GMP repress flagella synthesis through FleQ25, activating in turn genes for the production of exopolysaccharides related to biofilm formation32. Here we show that the SadB protein, a regulator involved in the control of flagella synthesis that acts upstream of FleQ, specifically binds c-di-GMP at physiological levels and with an affinity that is much higher than that of FleQ. Furthermore, another regulatory protein, AmrZ, has been shown to be a major determinant of c-di-GMP levels in P. fluorescens F113. In this bacterium, AmrZ acts as a transcriptional activator of genes encoding DGCs and other proteins associated with c-di-GMP turnover23.
Results presented here show that at least one AmrZ regulated DGC, AdrA, encoded by PSF113_1982 participates in the regulatory pathway resulting in flagella biogenesis. AdrA is a transmembrane protein with a conserved C-terminal GGDEF cytoplasmic domain and an N-terminal MASE2 integral membrane sensory domain. MASE2 domains have unknown function but are often found adjacent to GGDEF domains in bacterial signaling proteins27 (Fig. 1a). Although sequence homology is limited, the domain architecture of AdrA is identical to the AdrA protein in Salmonella typhimurium33 and its E. coli orthologue YaiC. Furthermore, the same transmembrane helices are present in the MASE2 domain. The signal detected by MASE2 domains is unknown, but this domain is often found associated with nucleotide cycling domains in DGCs and adenylate cyclases34. In E. coli and S. typhimurium, AdrA is a diguanylate cyclase implicated in c-di-GMP-mediated cellulose production and biofilm formation35. Results obtained in this study (Fig. 1b) indicate that in F113, AdrA could also act as a DGC. AdrA proteins are present in most strains of the Pseudomonas fluorescens group, one of the main clusters within the P. fluorescens complex of species36,37. Besides this group, AdrA orthologues are present in the genomes of P. syringae, P. putida and P. stutzeri, but absent in P. aeruginosa. To our knowledge, its relevance in swimming motility and/or biofilm formation has not been explored in strains other than P. fluorescens F113. Previous analysis showed that in P. fluorescens F113, AdrA is involved in swimming and biofilm formation, since inactivation of the adrA gene resulted in increased swimming motility and a reduction in the initial stages of attachment to surfaces23. Furthermore, to confirm that AdrA acts as a DGC we have carried out the overexpression of this gene in E. coli DH5α and F113, resulting in a substantial decrease in swimming motility comparable to the effect described for the DGC SadC (Fig. 1b)20. Results show its implication in flagellar gene expression, since an adrA mutant shows enhanced fliC expression. Additionally, genetic interaction between adrA and sadB indicates that, AdrA participates in the regulation of flagella biogenesis. The swimming motility phenotype of the sadB mutation is dominant, suggesting that AdrA might act upstream of SadB. Since AdrA is a predicted membrane protein with a putative sensory domain, this protein links SadB signaling with possible environmental signals. Consequently, our data suggest that AdrA acts upstream of SadB, in the regulatory cascade. Moreover, our data indicate that AdrA acts independently of the Gac system, which is also consistent with the activity of AdrA in the SadB branch of the signaling pathway10.
SadB has been described as a signal transduction protein that negatively regulates motility in P. aeruginosa38 and P. fluorescens28. SadB contains two domains that might be implicated in c-di-GMP binding, a HDOD domain and an YbaK like domain. The HDOD domain resembles the HD-GYP domain but lacks its characteristic c-di-GMP phosphodiesterase activity39. Proteins with HDOD domains have been studied in Xanthomonas campestris. The HdpA protein from this bacterium has been shown to be implicated in bacterial attachment40, while the GsmR protein has been confirmed to affect the transcription of genes involved in flagella synthesis, including fliC41. It is therefore likely that HDOD proteins play similar roles in X. campestris and P. fluorescens. However, the mechanistic role (s) of HDOD domain has not been established. The similarity of the HDOD domain with the HD-GYP domain and its lack of phosphodiesterase activity prompted Merritt and coworkers and Navazo and coworkers28,30 to suggest that the HDOD domain in SadB could bind c-di-GMP. Regarding the YbaK-like domain, which resembles the active sites of deacylases, its function is unknown. However, it seems to be important as insertions in either of the two domains abolish SadB function in P. aeruginosa42. In Haemophilus influenzae, structural analysis of its YbaK-containing protein has shown the presence of a putative binding site that might accommodate a nucleotide or oligonucleotide29. We have shown here that the SadB protein is able to bind c-di-GMP specifically and with high affinity. Since binding of c-di-GMP to FleQ protein and the implication of this messenger in the transcription of flagellar genes in pseudomonads has been already reported24,32, our finding establishes another checkpoint for c-di-GMP regulation, upstream in the pathway. It is interesting to note that the apparent affinity of SadB for c-di-GMP is about 30 times higher than the reported for FleQ25.
The results presented here allow us to modify the model for flagella synthesis regulation in P. fluorescens F113 presented earlier10. In the modified model (Fig. 5), two membrane bound signal transduction proteins, GacS and AdrA initiate the two branches of the pathway converging in AlgU. In the AdrA branch, c-di-GMP is produced by AdrA in response to unknown signals. This is sensed by SadB, which in turn activates algU transcription10, required for transcription of the fleQ transcriptional repressor AmrZ. AmrZ itself activates the transcription of the adrA gene23. Since the motility phenotype of the sadB mutant is stronger than the phenotype of the adrA mutant, it is likely that other factors act upon SadB, downstream of AdrA. On the other hand, it cannot be ruled out that c-di-GMP produced by AdrA could be sensed also by FleQ. However, the large difference in affinity for c-di-GMP between both proteins make this unlikely.
Hypothetical regulatory model for flagellar synthesis in Pseudomonas fluorescens F113. In this updated model, the transcriptional regulator AmrZ positively controls the expression of the gene encoding the transmembrane DGC AdrA. This DGC responds to unknown environmental signals and synthesizes the c-di-GMP that, when bound to SadB, is involved in the repression of the flagellar apparatus synthesis. SadB dimers bound to c-di-GMP activates the expression of the gene encoding the sigma factor AlgU, required for the expression of the gene encoding the global regulator AmrZ. From this point, the hub AmrZ/FleQ by means of a mutual transcriptional repression controls the expression of the flagellar biosynthesis genes. The Gac branch of the signaling pathway remains as described earlier10.
Methods
Strains and growth conditions
Bacterial strains and plasmids used in this study are listed in Supplementary Table 1. P. fluorescens F113 and derivatives were grown in Sucrose-Asparagine (SA) medium43 or Lysogeny Broth (LB) medium44 at 28 °C. Escherichia coli strains were grown in LB medium at 37 °C or 28 °C for protein overexpression. When required, the media were supplemented with agar (1.5%) and/or antibiotics. In the case of Pseudomonas strains: Rifampicin (Rif), 100 µg/mL; Tetracycline (Tet), 70 µg/mL; Kanamycin (Km), 50 µg/mL; Gentamicin (Gm), 3 µg/mL and Spectinomycin (Spc), 100 µg/mL. For E. coli strains the antibiotic concentrations were: Kanamycin (Km), 25 µg/mL; Tetracycline (Tet), 10 µg/mL; Gentamicin (Gm), 10 µg/mL and. Ampicillin (Amp), 100 µg/mL. For induction with pETNdeM-1145, β-D-thiogalactopyranoside (IPTG) was added to a final concentration of 0.5 mM.
Molecular procedures
Routine molecular methods, including plasmid DNA extraction, cloning, restriction digests, electrophoresis, purification of DNA fragments and sequencing were performed in accordance with standard procedures.
Mutants were obtained by homologous recombination of an amplified internal fragment of the gene, cloned into the suicide vectors pK18mobsacB46, pG18mob247 or pCR2.1 TOPO cloning (Life Technologies). Plasmids were mobilized into F113 by electroporation. Further information about mutant construction is shown in Supplementary Table 1. All mutants were checked by PCR and Southern blotting. Complementation of mutants and overexpression of genes was performed by expressing a wild-type copy of the gene in expression vector pBBR1MCS-5 (Supplementary Table 1)48,49.
Total RNA was extracted from P. fluorescens F113 and derivatives, grown in LB medium to exponential phase (OD600 = 0.8), following the instructions included in SV Total RNA Isolation System (Promega). The concentration and quality of RNA was determined using a Nanodrop spectrophotometer (Thermo Fisher Scientific). RNA integrity was confirmed on 0.8% (w/v) agarose gels. In addition, genomic DNA contamination in the samples was analysed by PCR. Complementary DNA (cDNA) synthesis by reverse transcription (RT-PCR) was performed using Superscript IV Reverse Transcriptase (Invitrogen) from 1 µg of extracted RNA. RT-qPCR analysis were carried out in triplicate for each gene using FastStart Universal SYBR Green Master Rox (Roche). Gene expression was normalized to the level of the endogenous housekeeping gene rpoZ and normalized to the wt reference sample following the 2−ΔΔCt method50.
Phenotypic analysis
Swimming motility assays were determined in SA (for P. fluorescens) or LB (for E. coli) plates containing 0.3% (w/v) purified agar as described before28. To induce expression of vector promoters, IPTG at 0.25 mM was used. Swimming haloes diameters were measured after 24 hours of incubation at 28 °C. Every assay was performed at least three times with three replicates in each experiment.
Biofilm formation assays were performed by a modified version of a previously described quantification method51. Briefly, overnight cultures grown in LB medium were adjusted to OD600 at 0.8 into fresh LB and statically incubated at 28 °C for 2 hours in 96-well-microlitre plates. Adhered cells were fixed with 99% methanol and stained with crystal violet. After washing and solubilization in acetic acid 33%, the absorbance of the eluted crystal violet was measured at OD590 on a Synergy HT multi-mode microplate reader (BioTek, Wilusky, VT, USA). Experiments were repeated three times with 16 technical replicates in each assay.
c-di-GMP level determination
Fluorescence intensity emitted by P. fluorescens F113 and its adrA mutant harbouring the pCdrA::gfpC biosensor vector52 was visualized with a Leica M165 FC stereomicroscope employing a GFP filter set (Excitation/Emission 494/518 nm) with different exposure times. Pictures were collected with an exposure time elapsed to 50 milliseconds through Leica Application Suite software.
Indirect quantitative determination of intracellular c-di-GMP from wt and adrA− strains harbouring pCdrA::gfpC vector was measured in 96-black well microplate assays, as described earlier23. Overnight cultures grown in LB medium were diluted to OD600 = 0.5 and fluorescence (excited at 485/20, emission at 528/20 nm) was measured in a Synergy HT multi-mode microplate reader (BioTek, Wilusky, VT, USA). Each experiment was performed in triplicate with 16 technical replicates.
Protein Purification
E. coli BL21 (DE3) pLysS strain overexpressing SadB was grown overnight and then used to inoculate the overexpression cultures in a 1:100 dilution. These were grown at 37 °C to an OD600 of 0.4 in Terrific Broth (TB), before protein expression was induced overnight with 0.5 mM IPTG at 18 °C. Cells were then lysed by sonication and centrifuged at 15,000 g for one hour. SadB was purified from the supernatant by NTA-Ni chromatography using 1 mL HiTrap chelating HP columns (GE healthcare, life sciences). The columns were equilibrated with 10 volumes of washing buffer (20 mM HEPES pH 7.5, 250 mM NaCl, 2 mM MgCl2, and 2.5% (v/v) glycerol pH 6.8) and loaded with cell lysate. Following protein immobilization, the column was washed with 10 volumes of buffer containing 50 mM imidazole, before proteins were eluted using 500 mM imidazole buffer in a single step elution.
Surface plasmon resonance (SPR)
The method was conducted as described by Trampari and coworkers19. SPR experiments were done at 25 °C with a Biacore T200 system (GE Healthcare) using a Streptavidin SA sensor chip (GE healthcare), which has four flow cells each containing SA pre-immobilized to a carboxymethylated dextran matrix. The chip was first washed three times with 1 M NaCl, 50 mM NaOH to remove any unconjugated streptavidin. 100 nM biotinylated c-di-GMP (BioLog B098) was immobilised on FC2 and FC4 of the streptavidin chip at a 50 RU immobilisation level with a flow rate of 5 μL/min. Flow cell one (FC1) and flow cell three (FC3) were kept blank to use for reference subtraction. Soluble SadB protein was prepared in SPR buffer (10 mM HEPES, 500 mM NaCl, 0.1% (v/v) Tween 20, 2 mM MgCl2, pH 6.8). Samples were injected with a flow rate of 5 μL/min over the reference and c-di-GMP cells for 60 seconds followed by buffer flow for 60 seconds. The chip was washed at the end of each cycle with 1 M NaCl. An increasing range of protein concentrations (78.125 nM, 156.25 nM, 312.5 nM, 625 nM, 1.25 µM, 2.5 µM, 5.0 µM, 10 μΜ) was used, with replicates for each protein concentration included as appropriate. All sensorgrams were analysed using Biacore T200 BiaEvaluation software version 1.0 (GE Healthcare). Data were then plotted using Microsoft Excel and GraphPad Prism 7.00 (GraphPad software, La Jolla, California, USA). The experiment was repeated three times independently.
Biotinylated c-di-GMP pull-down experiment
For the overexpression of SadB 5 mL cultures were induced overnight at 18 °C using 0.5 mM IPTG. The cells were lysed by sonication and centrifuged for 30 minutes at 13,000 g. 45 μL of the soluble fraction was collected and mixed with biotinylated c-di-GMP (BioLog B098) at a final concentration of 30 μM. The mixture was then incubated overnight on a rotary wheel at 8 °C. For the stabilisation of any complex formation UV cross-linking was carried out using a UV Stratalinker (Stratagene) for 4 minutes on ice. 25 μL of streptavidin magnetic beads (Invitrogen) were then added into the mixture which was then incubated for 1 hour on a rotary wheel at 8 °C. A magnet was used to isolate the streptavidin magnetic beads and five washing steps were carried out using 200 μL of the protein washing buffer each time (20 mM HEPES pH 7.5, 250 mM NaCl, 2 mM MgCl2, and 2.5% (v/v) glycerol pH 6.8), to get rid of the non-specific c-di-GMP binding proteins. The washed streptavidin beads were resuspended in 15 μL protein washing buffer, 4x SDS loading dye was added and the samples were incubated at 95 °C for 10 minutes before loaded in a 12% SDS-PAGE protein gel. The gel was then developed using InstantBlue (Expedeon). GTP and c-di-GMP controls were added at 1 mM final concentration.
Statistical analysis
GraphPad Prism 7.00 (GraphPad software, La Jolla, California, USA) was used for the statistical analysis. The comparison was done using one-way analysis of variance (ANOVA) followed by Tukey’s correction of multiple comparison test (p ≤ 0.05).
Change history
16 January 2021
The previously published version of this Article contained an error, where the link to its accompanying Supplementary Information file led to an incorrect file. This has now been corrected in the HTML version of the Article; the PDF version was correct at time of publication.
References
DeFlaun, M. F., Marshall, B. M., Kulle, E. P. & Levy, S. B. Tn5 insertion mutants of Pseudomonas fluorescens defective in adhesion to soil and seeds. Appl Environ Microbiol 60, 2637–2642 (1994).
O’Toole, G. A. & Kolter, R. Initiation of biofilm formation in Pseudomonas fluorescens WCS365 proceeds via multiple, convergent signalling pathways: a genetic analysis. Mol Microbiol 28, 449–461 (1998).
de Weert, S. et al. Flagella-driven chemotaxis towards exudate components is an important trait for tomato root colonization by Pseudomonas fluorescens. Mol Plant Microbe Interact 15, 1173–1180, https://doi.org/10.1094/MPMI.2002.15.11.1173 (2002).
Capdevila, S., Martínez-Granero, F. M., Sánchez-Contreras, M., Rivilla, R. & Martín, M. Analysis of Pseudomonas fluorescens F113 genes implicated in flagellar filament synthesis and their role in competitive root colonization. Microbiology 150, 3889–3897, https://doi.org/10.1099/mic.0.27362-0 (2004).
Muriel, C., Jalvo, B., Redondo-Nieto, M., Rivilla, R. & Martín, M. Chemotactic motility of Pseudomonas fluorescens F113 under aerobic and denitrification conditions. PLoS One 10, e0132242, https://doi.org/10.1371/journal.pone.0132242 (2015).
Martínez-Granero, F., Rivilla, R. & Martín, M. Rhizosphere selection of highly motile phenotypic variants of Pseudomonas fluorescens with enhanced competitive colonization ability. Appl Environ Microbiol 72, 3429–3434, https://doi.org/10.1128/AEM.72.5.3429-3434.2006 (2006).
Barahona, E. et al. Efficient rhizosphere colonization by Pseudomonas fluorescens f113 mutants unable to form biofilms on abiotic surfaces. Environ Microbiol 12, 3185–3195, https://doi.org/10.1111/j.1462-2920.2010.02291.x (2010).
Arora, S. K., Ritchings, B. W., Almira, E. C., Lory, S. & Ramphal, R. A transcriptional activator, FleQ, regulates mucin adhesion and flagellar gene expression in Pseudomonas aeruginosa in a cascade manner. J Bacteriol 179, 5574–5581 (1997).
Dasgupta, N. et al. A four-tiered transcriptional regulatory circuit controls flagellar biogenesis in Pseudomonas aeruginosa. Molecular microbiology 50, 809–824 (2003).
Martínez-Granero, F. et al. The Gac-Rsm and SadB signal transduction pathways converge on AlgU to downregulate motility in Pseudomonas fluorescens. PLoS One 7, e31765, https://doi.org/10.1371/journal.pone.0031765 (2012).
Martínez-Granero, F., Redondo-Nieto, M., Vesga, P., Martín, M. & Rivilla, R. AmrZ is a global transcriptional regulator implicated in iron uptake and environmental adaption in P. fluorescens F113. BMC Genomics 15, 237, https://doi.org/10.1186/1471-2164-15-237 (2014).
Jones, C. J. et al. ChIP-Seq and RNA-Seq reveal an AmrZ-mediated mechanism for cyclic di-GMP synthesis and biofilm development by Pseudomonas aeruginosa. PLoS Pathog 10, e1003984, https://doi.org/10.1371/journal.ppat.1003984 (2014).
Tart, A. H., Blanks, M. J. & Wozniak, D. J. The AlgT-dependent transcriptional regulator AmrZ (AlgZ) inhibits flagellum biosynthesis in mucoid, nonmotile Pseudomonas aeruginosa cystic fibrosis isolates. J Bacteriol 188, 6483–6489, https://doi.org/10.1128/JB.00636-06 (2006).
Hengge, R. Principles of c-di-GMP signalling in bacteria. Nat Rev Microbiol 7, 263–273, https://doi.org/10.1038/nrmicro2109 (2009).
Simm, R. et al. domains inversely regulate cyclic di-GMP levels and transition from sessility to motility. Mol Microbiol 53, 1123–1134, https://doi.org/10.1111/j.1365-2958.2004.04206.x (2004).
Tal, R. et al. Three cdg operons control cellular turnover of cyclic di-GMP in Acetobacter xylinum: genetic organization and occurrence of conserved domains in isoenzymes. J Bacteriol 180, 4416–4425 (1998).
Ausmees, N. et al. Genetic data indicate that proteins containing the GGDEF domain possess diguanylate cyclase activity. FEMS Microbiol Lett 204, 163–167 (2001).
Aravind, L. & Koonin, E. V. The HD domain defines a new superfamily of metal-dependent phosphohydrolases. Trends in biochemical sciences 23, 469–472 (1998).
Trampari, E. et al. Bacterial rotary export ATPases are allosterically regulated by the nucleotide second messenger cyclic-di-GMP. J Biol Chem 290, 24470–24483, https://doi.org/10.1074/jbc.M115.661439 (2015).
Martínez-Granero, F. et al. Identification of flgZ as a flagellar gene encoding a PilZ domain protein that regulates swimming motility and biofilm formation in Pseudomonas. PLoS One 9, e87608, https://doi.org/10.1371/journal.pone.0087608 (2014).
Baker, A. E. et al. PilZ domain protein FlgZ mediates cyclic di-GMP-dependent swarming motility control in Pseudomonas aeruginosa. J Bacteriol 198, 1837–1846, https://doi.org/10.1128/JB.00196-16 (2016).
Petrova, O. E., Cherny, K. E. & Sauer, K. The Pseudomonas aeruginosa diguanylate cyclase GcbA, a homolog of P. fluorescens GcbA, promotes initial attachment to surfaces, but not biofilm formation, via regulation of motility. J Bacteriol 196, 2827–2841, https://doi.org/10.1128/JB.01628-14 (2014).
Muriel, C. et al. AmrZ is a major determinant of c-di-GMP levels in Pseudomonas fluorescens F113. Sci Rep 8, 1979, https://doi.org/10.1038/s41598-018-20419-9 (2018).
Hickman, J. W. & Harwood, C. S. Identification of FleQ from Pseudomonas aeruginosa as a c-di-GMP-responsive transcription factor. Mol Microbiol 69, 376–389, https://doi.org/10.1111/j.1365-2958.2008.06281.x (2008).
Baraquet, C. & Harwood, C. S. Cyclic diguanosine monophosphate represses bacterial flagella synthesis by interacting with the Walker A motif of the enhancer-binding protein FleQ. Proc Natl Acad Sci USA 110, 18478–18483, https://doi.org/10.1073/pnas.1318972110 (2013).
Finn, R. D. et al. HMMER web server: 2015 update. Nucleic Acids Res 43, W30–38, https://doi.org/10.1093/nar/gkv397 (2015).
Nikolskaya, A. N., Mulkidjanian, A. Y., Beech, I. B. & Galperin, M. Y. MASE1 and MASE2: two novel integral membrane sensory domains. J Mol Microbiol Biotechnol 5, 11–16, https://doi.org/10.1159/000068720 (2003).
Navazo, A. et al. Three independent signalling pathways repress motility in Pseudomonas fluorescens F113. Microb Biotechnol 2, 489–498, https://doi.org/10.1111/j.1751-7915.2009.00103.x (2009).
Zhang, H. et al. Crystal structure of YbaK protein from Haemophilus influenzae (HI1434) at 1.8 A resolution: functional implications. Proteins 40, 86–97 (2000).
Merritt, J. H., Brothers, K. M., Kuchma, S. L. & O’Toole, G. A. SadC reciprocally influences biofilm formation and swarming motility via modulation of exopolysaccharide production and flagellar function. J Bacteriol 189, 8154–8164, https://doi.org/10.1128/JB.00585-07 (2007).
Blanco-Romero, E. et al. Genome-wide analysis of the FleQ direct regulon in Pseudomonas fluorescens F113 and Pseudomonas putida KT2440. Sci Rep 8, 13145, https://doi.org/10.1038/s41598-018-31371-z (2018).
Baraquet, C., Murakami, K., Parsek, M. R. & Harwood, C. S. The FleQ protein from Pseudomonas aeruginosa functions as both a repressor and an activator to control gene expression from the pel operon promoter in response to c-di-GMP. Nucleic Acids Res 40, 7207–7218, https://doi.org/10.1093/nar/gks384 (2012).
Römling, U., Rohde, M., Olsén, A., Normark, S. & Reinköster, J. AgfD, the checkpoint of multicellular and aggregative behaviour in Salmonella typhimurium regulates at least two independent pathways. Mol Microbiol 36, 10–23 (2000).
Topal, H. et al. Crystal structure and regulation mechanisms of the CyaB adenylyl cyclase from the human pathogen Pseudomonas aeruginosa. J Mol Biol 416, 271–286, https://doi.org/10.1016/j.jmb.2011.12.045 (2012).
Cowles, K. N., Willis, D. K., Engel, T. N., Jones, J. B. & Barak, J. D. Diguanylate xyclases AdrA and STM1987 regulate Salmonella enterica exopolysaccharide production during plant colonization in an environment-dependent manner. Appl Environ Microbiol 82, 1237–1248, https://doi.org/10.1128/AEM.03475-15 (2016).
Garrido-Sanz, D. et al. Genomic and genetic diversity within the Pseudomonas fluorescens complex. PLoS One 11, e0150183, https://doi.org/10.1371/journal.pone.0150183 (2016).
Garrido-Sanz, D. et al. Classification of isolates from the Pseudomonas fluorescens complex into phylogenomic groups based in group-specific markers. Front Microbiol 8, 413, https://doi.org/10.3389/fmicb.2017.00413 (2017).
Caiazza, N. C., Shanks, R. M. & O’Toole, G. A. Rhamnolipids modulate swarming motility patterns of Pseudomonas aeruginosa. J Bacteriol 187, 7351–7361, https://doi.org/10.1128/JB.187.21.7351-7361.2005 (2005).
Galperin, M. Y. Bacterial signal transduction network in a genomic perspective. Environ Microbiol 6, 552–567, https://doi.org/10.1111/j.1462-2920.2004.00633.x (2004).
Lee, H. M. et al. Characterization of genes encoding proteins containing HD-related output domain in Xanthomonas campestris pv. campestris. Antonie Van Leeuwenhoek 109, 509–522, https://doi.org/10.1007/s10482-016-0656-y (2016).
Liu, Y. F. et al. GsmR, a response regulator with an HD-related output domain in Xanthomonas campestris, is positively controlled by Clp and is involved in the expression of genes responsible for flagellum synthesis. FEBS J 280, 199–213, https://doi.org/10.1111/febs.12061 (2013).
Caiazza, N. C. & O’Toole, G. A. SadB is required for the transition from reversible to irreversible attachment during biofilm formation by Pseudomonas aeruginosa PA14. J Bacteriol 186, 4476–4485, https://doi.org/10.1128/JB.186.14.4476-4485.2004 (2004).
Scher, F. M. & Baker, R. Effect of Pseudomonas putida and a synthetic iron chelator on induction of soil suppressiveness to Fusarium wilt pathogens. Phytopathology 72, 1567–1573, https://doi.org/10.1094/Phyto-72-1567 (1982).
Bertani, G. A method for detection of mutations, using streptomycin dependence in Escherichia coli. Genetics 36, 598–611 (1951).
Little, R., Salinas, P., Slavny, P., Clarke, T. A. & Dixon, R. Substitutions in the redox-sensing PAS domain of the NifL regulatory protein define an inter-subunit pathway for redox signal transmission. Mol Microbiol 82, 222–235, https://doi.org/10.1111/j.1365-2958.2011.07812.x (2011).
Schäfer, A. et al. Small mobilizable multi-purpose cloning vectors derived from the Escherichia coli plasmids pK18 and pK19: selection of defined deletions in the chromosome of Corynebacterium glutamicum. Gene 145, 69–73 (1994).
Kirchner, O. & Tauch, A. Tools for genetic engineering in the amino acid-producing bacterium Corynebacterium glutamicum. J Biotechnol 104, 287–299 (2003).
Kovach, M. E. et al. Four new derivatives of the broad-host-range cloning vector pBBR1MCS, carrying different antibiotic-resistance cassettes. Gene 166, 175–176 (1995).
Heeb, S., Blumer, C. & Haas, D. Regulatory RNA as mediator in GacA/RsmA-dependent global control of exoproduct formation in Pseudomonas fluorescens CHA0. J Bacteriol 184, 1046–1056 (2002).
Livak, K. J. & Schmittgen, T. D. Analysis of relative gene expression data using real-time quantitative PCR and the 2(-Delta Delta C(T)) Method. Methods 25, 402–408, https://doi.org/10.1006/meth.2001.1262 (2001).
Peeters, E., Nelis, H. J. & Coenye, T. Comparison of multiple methods for quantification of microbial biofilms grown in microtiter plates. J Microbiol Methods 72, 157–165, https://doi.org/10.1016/j.mimet.2007.11.010 (2008).
Rybtke, M. T. et al. Fluorescence-based reporter for gauging cyclic di-GMP levels in Pseudomonas aeruginosa. Appl Environ Microbiol 78, 5060–5069, https://doi.org/10.1128/AEM.00414-12 (2012).
Acknowledgements
We wish to thank Dr. Maribel Ramos and Ms. Maria Luisa Travieso (Estación Experimental del Zaidín, CSIC) for the help with the pCdrA biosensor. This work was supported by funding from MINECO/FEDER EU Grant RTI2018 093991-BI00 to R.R. and M.M. C.M. was funded by a FPI fellowship from MINECO. EB-R was the recipient of fellowships from Fundación Tatiana Pérez de Guzmán el Bueno (Medioambiente 2016) and the FPU program from MECD (FPU16/05513). Short stays of R.R. and C.M. at John Innes Centre were funded by MECD (Salvador de Madariaga and FPU, respectively).
Author information
Authors and Affiliations
Contributions
R.R. and M.M. conceived and designed the study, supervised research and wrote the manuscript. J.G.M. supervised research at J.I.C. C.M., E.B.-R., E.T., E.A. and D.D. designed and performed experiments. M.R.-N. performed bioinformatic analysis. All authors revised the final manuscript.
Corresponding author
Ethics declarations
Competing Interests
The authors declare no competing interests.
Additional information
Publisher’s note: Springer Nature remains neutral with regard to jurisdictional claims in published maps and institutional affiliations.
Supplementary information
Rights and permissions
Open Access This article is licensed under a Creative Commons Attribution 4.0 International License, which permits use, sharing, adaptation, distribution and reproduction in any medium or format, as long as you give appropriate credit to the original author(s) and the source, provide a link to the Creative Commons license, and indicate if changes were made. The images or other third party material in this article are included in the article’s Creative Commons license, unless indicated otherwise in a credit line to the material. If material is not included in the article’s Creative Commons license and your intended use is not permitted by statutory regulation or exceeds the permitted use, you will need to obtain permission directly from the copyright holder. To view a copy of this license, visit http://creativecommons.org/licenses/by/4.0/.
About this article
Cite this article
Muriel, C., Blanco-Romero, E., Trampari, E. et al. The diguanylate cyclase AdrA regulates flagellar biosynthesis in Pseudomonas fluorescens F113 through SadB. Sci Rep 9, 8096 (2019). https://doi.org/10.1038/s41598-019-44554-z
Received:
Accepted:
Published:
DOI: https://doi.org/10.1038/s41598-019-44554-z
- Springer Nature Limited
This article is cited by
-
Extracytoplasmic sigma factor AlgU contributes to fitness of Pseudomonas aeruginosa PGPR2 during corn root colonization
Molecular Genetics and Genomics (2022)